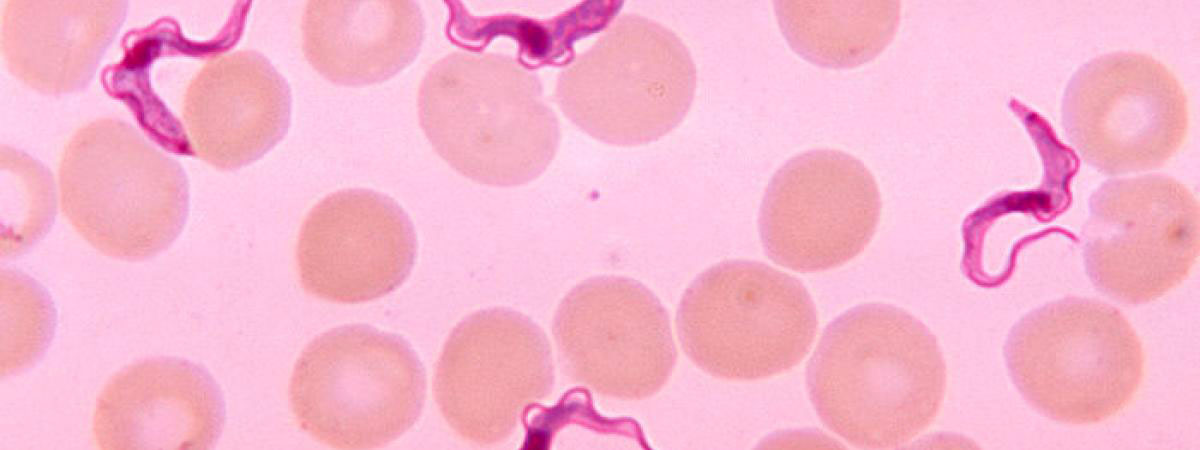

Peut-être pensez-vous que les seuls endroits où vous êtes susceptible de rencontrer des parasites dangereux sont les pays exotiques… Détrompez-vous, avec la mondialisation, notre nourriture nous parvient des quatre coins du monde et comporte parfois quelques surprises qui ne sont pas des plus agréables… Le top 10 à découvrir ci-dessous.
Rassurez-vous cependant, une bonne hygiène suffit la plupart du temps à vous débarrasser de ce genre de vermine. Un petit coup d’eau sur vos fruits et légumes avant de les consommer, une bonne cuisson pour la viande et le poisson, et vous vous mettez en sécurité ! Cependant, un petit parasite peut parfois survivre, et des problèmes surviennent. Cela, l’ONU et l’OMS l’ont bien compris, c’est pourquoi ils ont décidé de prévenir plutôt que de guérir et tentent actuellement d’assurer des mesures d’hygiène plus restrictives sur les exportations alimentaires internationales. Les deux organisations ont demandé à un groupe d’experts de répertorier les 24 parasites les plus répandues qui se cachent parfois dans notre nourriture.
1. Trichinella spiralis
La bactérie Trichinella spiralis se retrouve dans la viande de porc ou dans le gibier tel que le sanglier. La contamination, elle, se fait par ingestion de ce genre d’aliment lorsqu’il n’est pas assez cuit, causant la maladie de trichinellose. Après ingestion de nourriture contaminée, des larves viennent infester le corps humain, et celles-ci se dirigent vers les tissus musculaires pour les manger petit à petit. Dans le cas de la femme ci-dessus, ce sont les muscles des yeux qui ont été atteints, lui causant ainsi des difficultés pour les ouvrir.
2. Trypanosoma cruzi
Ce petit parasite est friand de sang humain, il lui arrive donc de se promener à la surface de notre peau pendant la nuit, en espérant arriver à nous mordre pour nous extirper notre précieux liquide rouge. Mais les choses se compliquent lorsque, parfois, après nous avoir mordu, l’insecte défèque sur notre peau. Si ces défécations parviennent à pénétrer notre organisme, souvent par le biais de la plaie, il y a un risque d’infection, qui provoque alors la maladie de Chagas. Le principal effet de cette maladie est de créer des insuffisances de régénération cellulaire dans certaines parties du corps, et notamment au niveau du coeur, ce qui peut parfois (mais rarement) provoquer des arrêts cardiaques mortels au contaminé.
3. Ascaris
Ces vers intestinaux sont les plus gros qui puissent infecter l’homme (il peuvent atteindre 35 cm de longueur). Avec environ 25 % de la population mondiale infectée par ces vers, c’est le parasite que l’on retrouve le plus couramment dans le corps humain. Fort heureusement, il est loin d’être le plus dangereux. L’ampleur des symptômes peut varier selon le nombre de vers présents dans le corps du sujet, mais le risque majeur de ce genre d’infection est un simple blocage intestinal, dû à la taille grandissante de ces vers dans l’intestin.
4. Toxoplasma gondii
On retrouve ce parasite dans de nombreux pays, ce qui en fait le parasite protozoaire le plus répandu dans le monde. Il se transmet notamment par les animaux de compagnie et plus particulièrement les chats. En général, les larves se contentent de rester dans les tissus et leur présence n’affecte pas le fonctionnement de l’organisme, ce qui signifie que la majorité des gens qui sont infectés ne le savent pas car ils n’ont pas de symptômes. Cependant, le parasite peut devenir dangereux pour les femmes enceintes puisque les larves peuvent traverser le placenta et atteindre le bébé, causant alors parfois des malformations.
5. Taenia solium
On peut être infecté par le Taenia solium en mangeant de la viande qui n’est pas assez cuite. La maladie causée par ce parasite se limite souvent à des problèmes nutritionnels puisque la larve, qui grandit dans l’estomac et dans les intestins se nourrit de ce que l’humain ingère. Ainsi, plus la larve consomme de nourriture, moins le malade en consomme. Lorsque les larves croissent, elles migrent dans d’autres parties du corps et la maladie s’aggrave alors. Il arrive qu’elles migrent près de l’encéphale et peuvent ainsi causer des crises d’épilepsie chez le contaminé, parfois mortelles.
6. Opisthorchiidae
Cet agent infectieux se retrouve majoritairement en Asie du Sud-Est (bien que certaines espèces soient relativement répandues en Russie et en Europe). La maladie se contracte en consommant du poisson d’eau douce qui n’a pas été assez cuit et se répand dans la vésicule biliaire. Une infection sur le long terme peut provoquer des cancers du foie et de la vésicule biliaire.
7. Entamoeba histolytica
Ce parasite affecte le système digestif et peut causer une amibiase. La maladie se caractérise par des diarrhées en sang et des douleurs abdominales. En cas d’aggravation de la maladie, cela peut causer des abcès au foie.
8. Echinococcus multilocularis
La répartition géographique de cette infection est difficile à déterminer, cependant, elle est plus largement répandue en Amérique du Nord et en Europe. Elle se retrouve en général chez les renards et les rongeurs mais aussi les animaux de compagnie tels que les chiens ou les chats. L’infection est à l’origine de la maladie d’échinococcose, à l’origine de l’apparition de kystes sur les organes internes qui peuvent occasionnellement se transformer en tumeurs et donc provoquer des cancers. C’est le cas du rat ci-dessus.
9. Echinococcus granulosus
Cette bactérie peut également être à l’origine de la contraction de la maladie d’échinococcose chez le contaminé. Ce parasite est surtout présent dans des troupeaux de moutons ou autres animaux de bétail. Ainsi, on recense plus d’un million de nouveaux cas dans le monde par an. Cependant, les symptômes n’apparaissent souvent que quelques années plus tard, sous forme de kyste.
10. Cryptosporidium
Ces agents infectieux protozoaires s’ingèrent par consommation d’une eau infectée, en lavant des aliments avec une eau non traitée, ou même en buvant du lait ou du cidre non pasteurisé. Cette bactérie est très répandue, et particulièrement en Europe. Cependant, elle est peu dangereuse puisque son seul effet est de causer des diarrhées. Pour éviter ce genre de désagrément, il est donc vivement conseillé de bien laver ses aliments avant de les consommer, mais surtout avec de l’eau propre !
Ces parasites sont vraiment dégoûtants… On aimerait essayer de les oublier pour continuer à manger sereinement. Heureusement, en respectant quelques règles d’hygiène, il est facile d’écarter les dangers les plus importants. Pensiez-vous que même nos aliments les plus traditionnels cachaient ce genre de bactéries ?